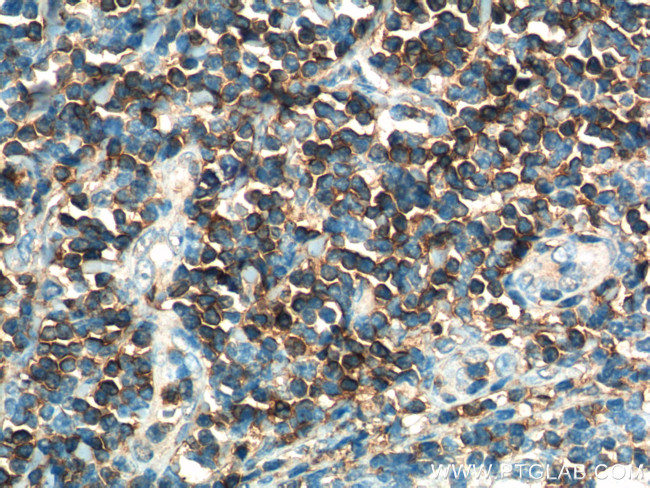
CD3 gamma Antibody in Immunohistochemistry (Paraffin) (IHC (P))

Search
Proteintech
CD3 gamma Monoclonal Antibody (2E9G7)
{{$productOrderCtrl.translations['antibody.pdp.commerceCard.promotion.promotions']}}
{{$productOrderCtrl.translations['antibody.pdp.commerceCard.promotion.viewpromo']}}
{{$productOrderCtrl.translations['antibody.pdp.commerceCard.promotion.promocode']}}: {{promo.promoCode}} {{promo.promoTitle}} {{promo.promoDescription}}. {{$productOrderCtrl.translations['antibody.pdp.commerceCard.promotion.learnmore']}}
产品信息
60347-1-IG
种属反应
宿主/亚型
分类
类型
克隆号
抗原
偶联物
形式
浓度
规格
纯化类型
保存液
内含物
保存条件
运输条件
产品详细信息
Immunogen sequence: QSIKGNHLV KVYDYQEDGS VLLTCDAEAK NITWFKDGKM IGFLTEDKKK WNLGSNAKDP RGMYQCKGSQ NKSKPLQVYY RMCQNCIELN AATISGFLFA EIVSIFVLAV GVYFIAGQDG VRQSRASDKQ TLLPNDQLYQ PLKDREDDQY SHLQGNQLRR N (23-182 aa encoded by BC113830)
靶标信息
CD3G is the CD3-gamma polypeptide, which together with CD3-epsilon, -delta and -zeta, and the T-cell receptor alpha/beta and gamma/delta heterodimers, forms the T-cell receptor-CD3 complex. This complex plays an important role in coupling antigen recognition to several intracellular signal-transduction pathways. The genes encoding the epsilon, gamma and delta polypeptides are located in the same cluster on chromosome 11. Defects in the CD3G gene are associated with T cell immunodeficiency.
仅用于科研。不用于诊断过程。未经明确授权不得转售。
生物信息学
蛋白别名: CD3g; CD3g antigen, gamma polypeptide (TiT3 complex); CD3g molecule, epsilon (CD3-TCR complex); CD3g molecule, gamma (CD3-TCR complex); T-cell antigen receptor complex, gamma subunit of T3; T-cell receptor T3 gamma chain; T-cell surface glycoprotein CD3 gamma chain; unnamed protein product
基因别名: CD3-GAMMA; CD3G; CD3GAMMA; IMD17; T3G
UniProt ID: (Human) P09693
Entrez Gene ID: (Human) 917